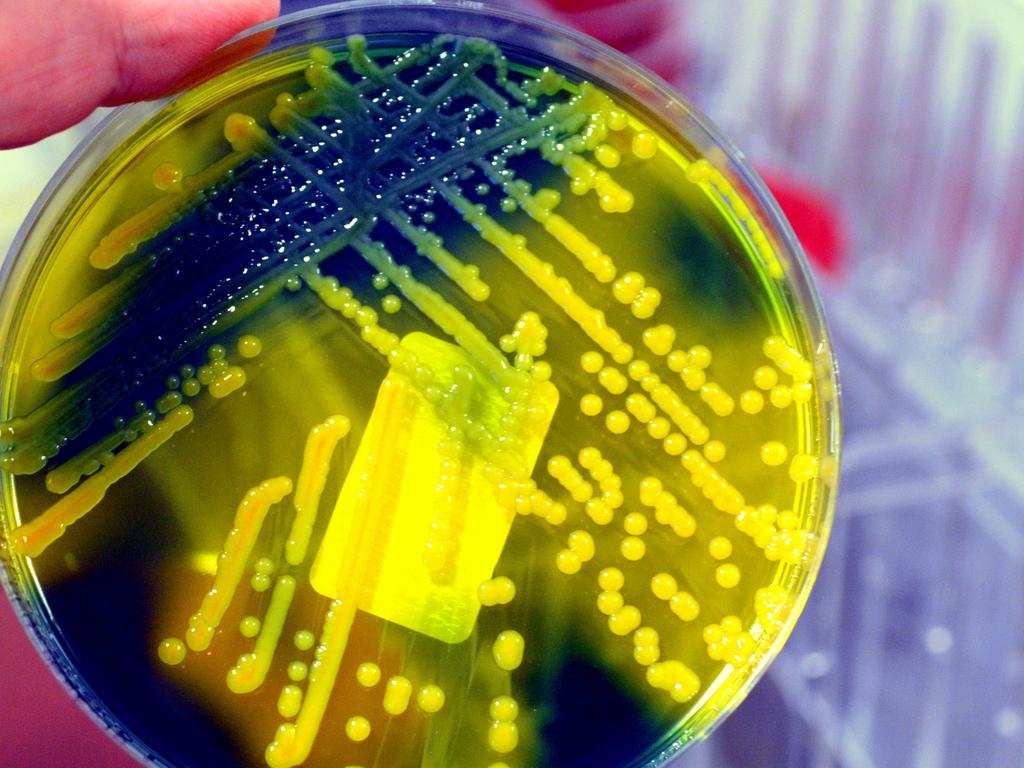

Renowned experts have sounded the alarm over a horrifying new deadly threat that is rapidly spreading across the globe.
Bombs, bullets and shrapnel are taking a terrible toll on the battlefields of Ukraine and Gaza. But an old opportunistic enemy is exploiting the carnage. Microbes. The battlefields have become a breeding ground for new, deadly, drug-resistant bacteria. It’s only to be expected.
Ukraine’s broad battlefields are littered with mud and corpses. Gaza is in ruins, with bombed-out sewage systems and bodies buried under the rubble. But people have to fight – and live – in these conditions. Open wounds are lucky to be cleaned, let alone receive urgent medical treatment. And once patients get to hospitals, these can be a minefield of infection.
“The environment that a war creates is like a feast for bacteria in which they quickly become resistant and are easily passed on,” Doctors Without Borders epidemiologist Krystel Moussally told Dutch media.

“Sometimes you receive 300 or 400 wounded people in half an hour. Then the cleaning of wounds is not optimal. It is an ideal vehicle for spreading infection.”
And just as drones and one-tonne bombs have changed the landscape of war, so too are rapidly evolving microbes.
“It’s eye-opening just how incredibly resistant some of the bacteria coming out of Ukraine are. I haven’t seen anything like it,” antibiotic resistance researcher Jason Bennett told the American Association for the Advancement of Science (AAAS).
Disease detectives
Evolution applies at even the most microscopic scale. And every new bacteriological “generation” emerges in less than an hour. It’s still a matter of survival of the fittest. Bacteria that learn how to defend themselves against antibiotics and other medical interventions will be the ones that spawn most of the next generation. And the next. And the next.
Military clinics in Ukraine and relief agencies in Gaza have registered a sharp increase in antimicrobial resistance (AMR) over the past year. Leading the charge is the bacteria Klebsiella pneumoniae. This bacteria is responsible for one in five deaths linked to antibiotic resistance globally.
The Lancet medical journal reported in September that AMR is killing more people than malaria or HIV. It forecasts it could be killing 10 million people annually by 2050.
Multidrug-resistant bacteria are circulating in #Gaza and #Ukraine. #Superbugs do not respond to #antibiotics and war victims are becoming increasingly difficult to treat! Nieuwsuur spoke to doctors 👇#AMR https://t.co/1TZzFv64vr
— The Global Antibiotics Resistance Foundation (@AntibioticsThe) July 24, 2024
So the World Health Organisation (WHO) is attempting to co-ordinate efforts to keep on top of the rapidly changing situation. The fear is these superbugs will soon spread beyond the breached borders of both Ukraine and Gaza. An early threat is a new, hypervirulent strain of Klebsiella pneumoniae. It’s infecting Ukrainian casualties. And it’s already resistant to treatment by any single known antibiotic.
Elsewhere, its less-virulent ancestors are already responsible for one in five global deaths attributed to AMR. The AAAS journal Science states Klebsiella infections create a tremendous amount of mucus in victims. And the outer layers of younger, drug-resistant bacteria act as a protective barrier to older generations thriving beneath. Now, examples of this new strain are reportedly beginning to emerge across Europe and even Japan.
Breeding grounds
Battlefield medics are “more likely to give broad-spectrum antibiotics” to wounded troops when the chances of immediate evacuation are low, Royal Centre for Defence Medicine microbiologist Scott Pallett told the AAAS. While well-intentioned, this can “add fuel to the fire” of rapid bacterial evolution.
“Frontline hospitals and triage clinics were throwing whatever they could at the injured soldiers to keep them alive,” says US Centres for Disease Control analyst Ezra Barzilay. “Antibiotic resistance was probably the last thing on their mind.”
But the problem doesn’t only apply on the battlefield, warns University of Western Australia researcher Christine Carson in The Conversation.
“Fewer controls over who has access to antibiotics in war-torn regions is also a problem,” she states.
“This includes using them ‘just in case’, using ones not effective for that infection or injury, or using them for too long, or not long enough.”
This is changing as the alarm spreads. But new strains have already taken hold. Clinics and hospitals must contend with regular power outages, staff shortages and erratic delivery of medical (and cleaning) supplies, allowing bacterial colonies to entrench themselves.
“Refugee camps and shelters for displaced populations are often overcrowded and lack access to clean water and proper sanitation,” adds Carson.
“So infections and resistant microbes are more likely to occur and spread, worsening outbreaks and fostering the evolution and spread of resistant microbes.”
Counter-attack
The WHO is working to establish a network of treatment clinics inside Ukraine to help compensate for the more than 2000 attacks on healthcare infrastructure by Russian forces since February 2022. And in Gaza, where all major hospitals and clinics have been the target of intensive operations by Israeli forces, UN organisations are rushing to take advantage of the ceasefire to restore some level of sanitation.
“Antimicrobial resistance in regions affected by conflict requires urgent action, as well as peace,” states Carson.
“This includes rebuilding and maintaining healthcare systems, improving sanitation, regulating antibiotic use, and ensuring access to clean water and vaccines.”
And that takes international co-operation, she adds.
“Without this, antimicrobial resistance becomes yet another catastrophic legacy of war, threatening human health and security for generations to come.”
Meanwhile, the race to develop new antibiotics and means of killing bacterial infections continues. Some progress is being made. But not enough.
The Biotechnology Innovation Organisation warned in 2022 that new treatments are not keeping pace with their resistant opponents.
Jamie Seidel is a freelance writer | @jamieseidel.bsky.social
